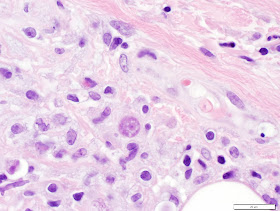

Several hairs from the groin region of a 24 year old male were submitted to the Clinical Parasitology lab for examination. One hair contained the following structure cemented onto the hair shaft. It measures approximately 2 mm in length. Identification?
Monday, February 24, 2014
Sunday, February 23, 2014
Answer to Case 293
Answer: nit (egg) of Pthirus pubis, the crab louse
You can differentiate this nit from the similarly appearing nits of the head and body lice by its taller operculum (cone of cells at the apex):
You can differentiate this nit from the similarly appearing nits of the head and body lice by its taller operculum (cone of cells at the apex):
And now a poem from Blaine Mathison (I'm not taking responsibility for this one!)
Chilling at home in his bachelor
pad
trying to get all the booty that
he could grab
but his latest of trysts
gave him a gift that persists
for now he's host to Sebastian
the 'Crab'
Tuesday, February 18, 2014
Case of the Week 292
Monday, February 17, 2014
Answer to Case 292
Answer: Trophozoites and Cysts of Acanthamoeba species/Balamuthia mandrillaris
A multiplex PCR for free-living amebae was also performed on this tissue, which was positive for Acanthamoeba sp. DNA.
Many of you noted that the organism morphology is characteristic for Acanthamoeba/Balamuthia (it is nearly impossible to tell the 2 apart by light microscopy, so I group them together) but mentioned that the skin is an unusual location for these organisms. It is correct that we don't usually see the free-living amebae in the skin. However, if you take a look at the CDC life cycle of Acanthamoeba and B. mandrillaris, you'll note that one port of entry to the blood stream (and eventually the brain) is broken skin. Therefore, it is essential to identify amebae in skin biopsies so that treatment can be implemented before dissemination occurs. In this case, note how the organisms are clustered around blood vessels, indicating their potential for hematogenous dissemination! Fortunately this patient did not have evidence of brain involvement.
A multiplex PCR for free-living amebae was also performed on this tissue, which was positive for Acanthamoeba sp. DNA.
Many of you noted that the organism morphology is characteristic for Acanthamoeba/Balamuthia (it is nearly impossible to tell the 2 apart by light microscopy, so I group them together) but mentioned that the skin is an unusual location for these organisms. It is correct that we don't usually see the free-living amebae in the skin. However, if you take a look at the CDC life cycle of Acanthamoeba and B. mandrillaris, you'll note that one port of entry to the blood stream (and eventually the brain) is broken skin. Therefore, it is essential to identify amebae in skin biopsies so that treatment can be implemented before dissemination occurs. In this case, note how the organisms are clustered around blood vessels, indicating their potential for hematogenous dissemination! Fortunately this patient did not have evidence of brain involvement.
Sunday, February 9, 2014
Case of the Week 291
The following was seen in a Giemsa-stained thick peripheral blood film from an immigrant from Congo. The patient reports focal swelling and tenderness in his left arm, but is otherwise asymptomatic.
(shown at 1000x magnification
(shown at 1000x magnification
Saturday, February 8, 2014
Answer to Case 291
Monday, February 3, 2014
Case of the Week 290
Sunday, February 2, 2014
Answer to Case 290
Answer: P. falciparum with early trophozoites (ring forms) and schizonts. Also shown (last photo) is a monocyte with malaria pigment (hemozoin). Although the differential diagnosis includes infection with 2 different Plasmodium species (notably with P. falciparum and P. malariae), the relatively high percent parasitemia and characteristics of the schizonts are most suggestive of a single infection with P. falciparum.
Marco Ligozzi mentions that "P. falciparum schizonts are rarely seen in the peripheral blood and their presence may indicate a potentially severe malaria." Similarly, Anonymous notes that "Urgent treatment is needed!"
Given the risk for severe, potentially overwhelming infection with P. falciparum, it is important to notify the clinical team immediately and explain the implication of finding P. falciparum schizonts in the peripheral blood. Fortunately this patient was treated immediately and responded well to treatment.
Marco Ligozzi mentions that "P. falciparum schizonts are rarely seen in the peripheral blood and their presence may indicate a potentially severe malaria." Similarly, Anonymous notes that "Urgent treatment is needed!"
Given the risk for severe, potentially overwhelming infection with P. falciparum, it is important to notify the clinical team immediately and explain the implication of finding P. falciparum schizonts in the peripheral blood. Fortunately this patient was treated immediately and responded well to treatment.